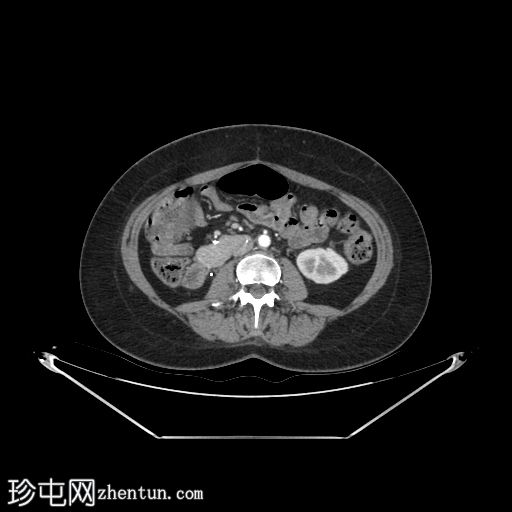
2.jpg

病例介绍
随访
患者资料
年龄:45岁
性别:女
CT
轴位
平扫

轴位增强扫描
动脉期
轴位增强扫描
门静脉期

冠状位增强扫描
门静脉期

矢状位增强扫描
门静脉期

自体肾脏和胰腺(胰头、胰体和胰尾)明显萎缩。
移植的胰腺位于右侧腹膜后间隙,大小和形态(轴位、冠状位和矢状位)均正常,可见相关手术缝合线。供体十二指肠段与自体十二指肠吻合。可见胰腺移植物与右髂血管的动脉吻合,胰腺实质强化均匀,提示移植物灌注良好。
左髂窝肾移植(轴位、冠状位),显示移植肾与同侧髂总血管的动脉和静脉吻合。移植肾形态完整,实质均匀强化。
病例讨论
胰肾联合移植(SPK)是治疗胰岛素依赖型糖尿病合并终末期肾病患者的成熟治疗方案,旨在通过一次手术恢复血糖正常和肾功能。该技术通常将移植肾植入髂窝,并与同侧髂血管进行动脉和静脉吻合,同时将移植胰腺置于对侧下腹部或腹膜后。胰腺外分泌引流最常用的方法是肠道改道,即用供体十二指肠段与受体自身肠道吻合。
本例中,影像学检查显示原位肾脏和胰腺明显萎缩,符合长期糖尿病合并慢性肾脏病的表现。肾移植位于左髂窝,与同侧髂血管的动脉和静脉吻合通畅,肾实质均匀强化,这些影像学表现均符合功能性肾移植的影像学特征。移植胰腺位于右侧腹膜后,形态和位置均符合原位胰腺,供体十二指肠袢与原位十二指肠吻合良好。 |